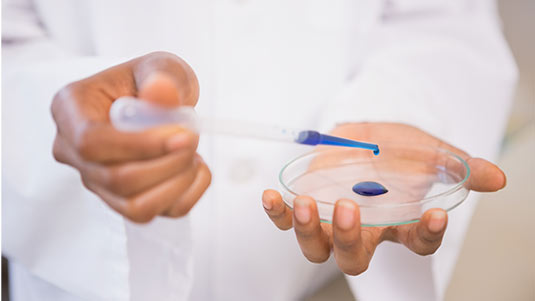

Oocyte and Sperm Donor Program
Donor Care for Parenthood
At Rusiya Fertility Centre, we understand that every fertility journey is unique. Our Oocyte and Sperm Donor Program is designed to help individuals and couples facing challenges with egg or sperm quality, or availability, achieve their dream of having a child. We provide safe, ethical, and confidential donor services tailored to your needs.

What is the Donor Program?
This program involves the use of donor eggs (oocytes) or donor sperm in fertility treatments like IVF or ICSI. It is a highly successful option when one or both partners are unable to produce healthy gametes or are at risk of passing on genetic conditions.
Treatment Process Overview

Consultation & Counseling
Discussion of options, legal and emotional considerations, and matching preferences.

Fertilization via IVF/ICSI
Donor eggs or sperm used in fertilization; embryos monitored in the lab.

Donor Matching & Preparation
Carefully selected donor and recipient cycle synchronization.

Embryo Transfer
Healthy embryos transferred to the uterus; pregnancy test follows in 2 weeks.

Who Can Benefit from Donor Eggs or Sperm?
- Women with low ovarian reserve or premature ovarian failure
- Women of advanced maternal age
- Men with no sperm production (azoospermia)
- Individuals with hereditary genetic disorders
- Same-sex couples and single parents
- Couples with repeated IVF failures due to poor egg/sperm quality
Donor Selection and Screening
We ensure all donors undergo strict medical, genetic, and psychological screening. Donor selection is conducted ethically, with attention to matching physical and blood characteristics, and in full confidentiality.
- Donor Oocytes: Retrieved from healthy, young women with proven fertility or good ovarian reserve.
- Donor Sperm: Sourced from licensed sperm banks or screened known donors, with detailed health and genetic profiles.

Skilled Hands, Compassionate Hearts
Dr. V. Anand Mohan
Founder
Kareem V.M
Managing Director
Dr. Bushera
Director of Operations &
Embryologist
Dr. Premu Johnson
Senior Consultant in Obstetrics & Gynecology
Dr. Balakrishnan
Senior Gynecologist &
Infertility Specialist
Dr Narayanan
Psychologist
Dr. Krishnaa Prakash
Consultant Sexologist
Ann Maria K.J
Junior Embryologist
Why Choose Rusiya Fertility Centre?
At Rusiya Fertility Centre, we offer ethical, confidential donor programs with thorough screening and careful matching. Our compassionate team provides complete emotional and legal support, ensuring a smooth experience. With high success rates and personalized, affordable packages, we are committed to helping you build your family with trust and care.
Ethical and confidential donor programs
Extensive donor screening and matching
Compassionate support for emotional and legal aspects
High success rates with donor-assisted IVF
Personalized, affordable treatment packages
RUSIYA
Fertility Center


RUSIYA
Fertility Center
Schedule a Consultation for Donor Program
Our Donor Program provides renewed hope for individuals and couples when other fertility options may not have succeeded. With access to carefully screened, healthy donors and advanced reproductive technologies, we offer a path forward with compassion, respect, and confidentiality. Our experienced team is here to guide and support you at every step, offering trusted care and expert insight as you move closer to achieving your dream of parenthood. Let us help you start this hopeful new chapter with confidence and peace of mind.
Frequently Asked Questions
Individuals or couples with poor egg/sperm quality, genetic conditions, or same-sex couples may benefit from donor gametes.
Yes. All donors undergo strict medical, genetic, and psychological screening to ensure safety and quality.
Absolutely. Donor and recipient identities remain confidential, following ethical and legal guidelines.
Yes. Matching is done based on physical traits, blood group, and other preferences, where possible.
Yes. Donor eggs/sperm from healthy individuals often improve success rates, especially when age or infertility is a factor.
Yes. Our program follows all legal, ethical, and medical standards as per Indian ART regulations.
- Copyright 2025 Rusiya Fertility Center.
Powered by SilverHost








